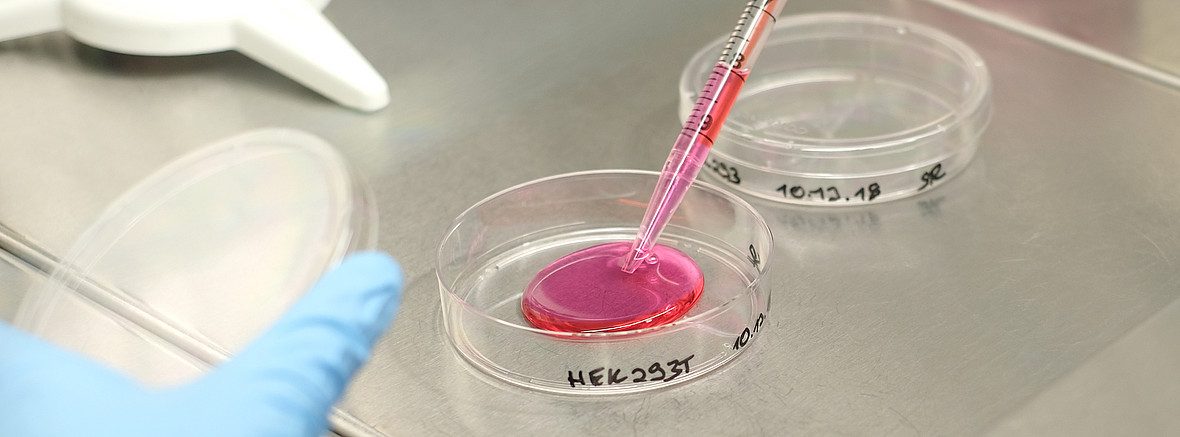

Praktisches Jahr
Während des Praktischen Jahres (PJ) können Studierende mindestens zwei Monate in der Klinik für Nephrologie als Teil Ihres Innere Tertials absolvieren. Dies kann einerseits auf der zentralen Notaufnahme oder auf der nephrologischen Station erfolgen.
Der PJ-Student begleitet den zuständigen Arzt und lernt, Entscheidungen im klinischen Alltag zu treffen. Zudem werden die Fähigkeiten zur klinischen Untersuchung, Blutabnahme, Anamneseerhebung sowie zu differentialdiagnostischen Überlegungen und zur Therapie geschult. Es wird gewünscht, dass PJ-Studierende unter Anleitung des zuständigen Arztes nach Einarbeitung eigenständig Patienten mitbetreuen. Während der Oberarzt- und Chefarztvisiten sowie in der Mittagsbesprechung sollen PJ-Studierende dann eigene Patienten vorstellen.


